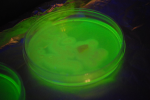

(from wikipedia)
Quote
Anisaldehyde is used as an intermediate in the synthesis of other compounds important in pharmaceuticals and perfumery, particularly ortho-anisaldehyde, which has a scent of licorice.I could be wrong, but I think by OTC he just means its readily available without a bunch of red tape.




 " not that I have a problem with that!
" not that I have a problem with that!

lol
lol